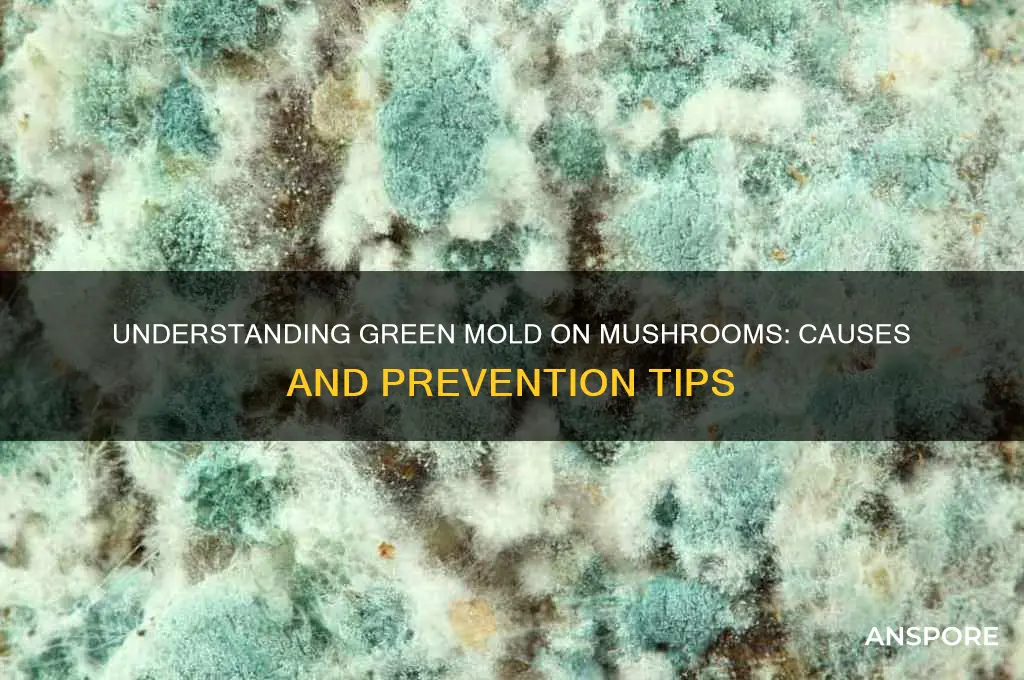
what causes green mold on mushrooms

Green mold on mushrooms is typically caused by the growth of various types of fungi, most commonly *Trichoderma* or *Penicillium* species, which thrive in damp, humid environments. These opportunistic fungi often colonize mushrooms when conditions are favorable, such as when the mushrooms are stored in high-moisture areas, have been damaged, or are past their prime. The green color results from the spores produced by these fungi, which can spread rapidly if not addressed. Poor ventilation, improper storage, and contamination during cultivation or handling also contribute to the development of green mold, making it essential to maintain clean, dry conditions to prevent its growth.
| Characteristics | Values |
|---|---|
| Cause | Green mold on mushrooms is primarily caused by Trichoderma species, a common fungus. |
| Environmental Conditions | High humidity (above 85%), poor air circulation, and temperatures between 20-30°C (68-86°F) promote growth. |
| Substrate Contamination | Contaminated growing substrates (e.g., straw, compost) can introduce Trichoderma spores. |
| Appearance | Green mold appears as a fuzzy, bright green growth on mushroom surfaces or substrates. |
| Spread | Rapidly spreads through airborne spores, contaminating nearby mushrooms or growing areas. |
| Prevention | Proper sterilization of substrates, maintaining optimal humidity, and good air circulation. |
| Impact on Mushrooms | Green mold competes with mushrooms for nutrients, stunting growth or causing decay. |
| Health Risks | Generally not harmful to humans but can indicate poor growing conditions. |
| Treatment | Affected mushrooms should be removed immediately; contaminated substrates must be discarded. |
| Common Species | Trichoderma harzianum and Trichoderma viride are frequently responsible. |
Explore related products
$13.48 $14.13
What You'll Learn
- High humidity levels promote mold growth on mushrooms due to excess moisture
- Poor air circulation traps dampness, fostering green mold development on mushroom surfaces
- Contaminated substrates introduce mold spores, leading to green mold outbreaks on mushrooms
- Improper storage conditions accelerate mold growth, especially in warm, dark environments
- Weakened mushroom tissues from pests or diseases make them susceptible to green mold

High humidity levels promote mold growth on mushrooms due to excess moisture
High humidity levels are a significant factor in the development of green mold on mushrooms, primarily due to the excess moisture that creates an ideal environment for mold spores to thrive. Mushrooms naturally retain moisture, and when the surrounding humidity is high, it exacerbates this moisture content, making the mushrooms more susceptible to mold growth. Mold spores, which are ubiquitous in the environment, require moisture to germinate and proliferate. In conditions of elevated humidity, these spores find the perfect breeding ground on the damp surfaces of mushrooms, leading to rapid mold colonization.
Excess moisture from high humidity not only provides the water mold needs to grow but also weakens the mushroom's natural defenses. Mushrooms have a delicate structure, and prolonged exposure to moisture can cause their tissues to break down, making them more vulnerable to mold infiltration. Additionally, high humidity slows down the evaporation of water from the mushrooms, ensuring that the environment remains consistently damp—a condition that mold thrives in. This prolonged dampness allows mold to establish itself firmly, often resulting in the green mold commonly observed on mushrooms.
To mitigate the risk of green mold, it is crucial to control humidity levels during mushroom cultivation and storage. Ideal humidity for mushrooms typically ranges between 80-90%, but exceeding this range can quickly lead to mold issues. Using dehumidifiers, ensuring proper ventilation, and regularly monitoring humidity levels can help maintain optimal conditions. For stored mushrooms, keeping them in a cool, dry place and using absorbent materials like paper towels can reduce excess moisture and inhibit mold growth.
Another instructive measure is to inspect mushrooms regularly for early signs of mold, especially in high-humidity environments. If mold is detected, affected mushrooms should be immediately removed to prevent spores from spreading to others. Proper spacing between mushrooms during growth or storage can also improve air circulation, reducing the likelihood of moisture accumulation. By addressing excess moisture directly, growers and consumers can significantly decrease the incidence of green mold on mushrooms.
In summary, high humidity levels promote green mold on mushrooms by providing the excess moisture that mold requires to grow and spread. Understanding this relationship is key to implementing effective preventive measures. By controlling humidity, improving air circulation, and monitoring mushrooms for early signs of mold, it is possible to protect mushrooms from the detrimental effects of excess moisture and maintain their quality.
Mushrooms and Cats: What You Need to Know
You may want to see also

Poor air circulation traps dampness, fostering green mold development on mushroom surfaces
Poor air circulation is a significant factor in the development of green mold on mushrooms, primarily because it traps dampness in the growing environment. Mushrooms thrive in humid conditions, but when air circulation is inadequate, moisture becomes stagnant, creating an ideal breeding ground for mold spores. These spores, which are naturally present in the air, settle on the mushroom surfaces and begin to grow rapidly in the presence of excess moisture. The lack of airflow prevents the evaporation of water, keeping the mushrooms and their surroundings perpetually wet, which is a critical condition for mold proliferation.
In environments with poor air circulation, such as tightly packed growing spaces or enclosed containers, the humidity levels often rise unchecked. This trapped dampness not only affects the mushrooms themselves but also the substrate and surrounding materials, all of which can become colonized by mold. Green mold, in particular, is a common culprit in such scenarios because it thrives in the same conditions that mushrooms prefer—cool, damp, and dark environments. Without proper ventilation, the mold gains a competitive advantage, outpacing the mushrooms in growth and eventually overtaking them.
To mitigate the risk of green mold caused by poor air circulation, growers must prioritize creating a well-ventilated environment. This can be achieved by spacing mushrooms adequately apart, using fans to promote airflow, or installing ventilation systems in enclosed growing areas. Ensuring that fresh air circulates freely helps reduce humidity levels and prevents moisture from accumulating on mushroom surfaces. Additionally, monitoring humidity levels with hygrometers allows growers to take corrective actions, such as dehumidifying the space, before conditions become conducive to mold growth.
Another practical measure is to avoid overcrowding mushrooms during cultivation. When mushrooms are too close together, they create microenvironments where air cannot flow freely, leading to localized pockets of high humidity. By maintaining proper spacing, growers can encourage air movement around each mushroom, reducing the likelihood of dampness and mold. Regularly inspecting the growing area for signs of excess moisture or mold and addressing issues promptly can also prevent the spread of green mold.
In summary, poor air circulation traps dampness, creating an environment where green mold flourishes on mushroom surfaces. By understanding this relationship, growers can implement strategies to improve airflow, manage humidity, and maintain optimal growing conditions. Proactive measures such as proper spacing, ventilation, and humidity control are essential in preventing mold and ensuring a healthy mushroom harvest. Addressing the root cause of trapped dampness is key to combating green mold and protecting mushroom crops from contamination.
Grow Magic Mushrooms: A Step-by-Step Guide
You may want to see also

Contaminated substrates introduce mold spores, leading to green mold outbreaks on mushrooms
Contaminated substrates are a primary culprit in the development of green mold on mushrooms, as they serve as a breeding ground for mold spores. Substrates, which are the materials used to grow mushrooms, can become contaminated during preparation, storage, or handling. Common contaminants include bacteria, fungi, and mold spores that are naturally present in the environment. When these spores come into contact with the substrate, they find an ideal environment to thrive, especially if the substrate is rich in organic matter and moisture. This contamination often goes unnoticed until the mold becomes visible, by which time it has already established a foothold.
The introduction of mold spores into the substrate can occur through various means, such as using unsterilized or improperly sterilized materials, exposure to contaminated air, or even through the hands and tools of the cultivator. For instance, if the growing environment is not kept clean or if the substrate is not adequately pasteurized or sterilized, mold spores can easily infiltrate. Once present, these spores germinate and grow rapidly, outcompeting the mushroom mycelium for nutrients. Green mold, often caused by species like *Trichoderma* or *Penicillium*, is particularly aggressive and can quickly colonize the substrate, leading to widespread contamination.
Preventing contaminated substrates is crucial to avoiding green mold outbreaks. Proper sterilization techniques, such as pressure cooking or pasteurization, are essential to eliminate mold spores and other contaminants before inoculation. Additionally, maintaining a clean growing environment, using sterile tools, and practicing good hygiene can significantly reduce the risk of introducing spores. Cultivators should also inspect substrates carefully before use and discard any that show signs of contamination, such as discoloration or unusual odors. These proactive measures can help ensure that the substrate remains free of mold spores, creating a healthier environment for mushroom growth.
Even with careful preparation, contamination can still occur, especially in environments where mold spores are prevalent. Monitoring the growing conditions regularly is vital to catch early signs of mold growth. If green mold is detected, immediate action is necessary to prevent it from spreading. This may involve isolating the affected mushrooms, removing contaminated substrate, and increasing ventilation to reduce humidity. In severe cases, the entire batch may need to be discarded to prevent further contamination. Understanding the role of contaminated substrates in mold outbreaks empowers cultivators to take targeted steps to protect their mushroom crops.
In summary, contaminated substrates are a significant source of mold spores that lead to green mold outbreaks on mushrooms. By focusing on proper substrate preparation, sterilization, and environmental cleanliness, cultivators can minimize the risk of contamination. Vigilance and early intervention are key to managing mold issues effectively. Addressing the root cause of contamination not only prevents green mold but also promotes healthier and more productive mushroom cultivation.
Button vs. Cremini Mushrooms: Which Variety Grows Larger?
You may want to see also
Explore related products

Improper storage conditions accelerate mold growth, especially in warm, dark environments
Improper storage conditions play a significant role in the development of green mold on mushrooms, particularly when they are kept in warm, dark environments. Mushrooms are highly perishable and require specific conditions to maintain their freshness. When stored in warm areas, the elevated temperature accelerates the metabolic processes of both the mushrooms and any present mold spores. This warmth creates an ideal breeding ground for mold, as it stimulates spore germination and rapid growth. Warmth also increases moisture evaporation from the mushrooms, which can condense in the storage container, creating a damp environment that further promotes mold proliferation.
Dark environments exacerbate the problem because mold thrives in the absence of light. Unlike some organisms that require light for growth, mold flourishes in darkness, where it can spread unchecked. When mushrooms are stored in dark places, such as unlit pantries or closed containers, mold spores are given the perfect conditions to colonize the surface of the mushrooms. The combination of warmth and darkness creates a synergistic effect, significantly shortening the time it takes for green mold to appear and spread.
Humidity is another critical factor influenced by improper storage conditions. Mushrooms naturally contain a high water content, and when stored in environments with poor air circulation, moisture can accumulate around them. Warm, dark spaces often lack ventilation, trapping humidity and creating a damp microclimate. This excess moisture on the mushroom surface provides the water mold needs to grow, while the warmth speeds up the process. Even slight increases in humidity can tip the balance in favor of mold development, making proper storage essential.
To prevent green mold, mushrooms should be stored in cool, well-lit, and ventilated areas. Refrigeration is the best method, as it slows down both the mushroom’s decay and mold growth. If refrigeration is not possible, storing mushrooms in a cool, dry place with exposure to indirect light can help. Additionally, mushrooms should be kept in breathable containers, such as paper bags or loosely wrapped in paper towels, to minimize moisture buildup. Avoiding plastic bags or airtight containers is crucial, as they trap moisture and create the warm, dark conditions that mold thrives in.
In summary, improper storage conditions, especially warm and dark environments, are a primary cause of green mold on mushrooms. Warmth accelerates mold growth by stimulating spore activity and creating condensation, while darkness provides an ideal setting for mold to flourish unchecked. Humidity, often exacerbated by poor ventilation in such environments, further fuels mold development. By understanding these factors and implementing proper storage practices, such as refrigeration, breathable packaging, and exposure to cool, dry conditions, the risk of green mold can be significantly reduced.
Dried vs. Fresh Mushrooms: Which Packs More Nutritional Punch?
You may want to see also

Weakened mushroom tissues from pests or diseases make them susceptible to green mold
Mushrooms, like any living organism, are susceptible to various pests and diseases that can weaken their tissues. When mushroom tissues are compromised, they become more vulnerable to secondary infections, including green mold. Pests such as mites, flies, and nematodes can physically damage the mushroom's surface, creating entry points for mold spores. For instance, mite infestations can cause tiny wounds on the mushroom caps, which disrupt the natural protective barriers. These weakened areas provide an ideal environment for green mold spores to germinate and colonize, as the mushroom's defense mechanisms are already compromised.
Diseases caused by fungi, bacteria, or viruses can also play a significant role in weakening mushroom tissues. Fungal pathogens like *Trichoderma* or bacterial infections such as *Pseudomonas* can degrade cell walls, making the mushroom more susceptible to green mold. Viral infections, though less common, can similarly stress the mushroom, reducing its ability to resist mold growth. When a mushroom is already battling a disease, its resources are diverted from growth and defense to combating the pathogen, leaving it more exposed to opportunistic molds like the green variety.
Environmental stressors often exacerbate the impact of pests and diseases on mushrooms, further increasing their susceptibility to green mold. Poor growing conditions, such as high humidity, inadequate ventilation, or improper substrate composition, can weaken mushrooms and make them more prone to both primary pathogens and secondary mold infections. For example, high humidity levels not only favor the growth of pests and diseases but also create a damp environment where green mold thrives. Thus, a combination of biological and environmental factors can create a perfect storm for green mold development on weakened mushroom tissues.
Preventing green mold starts with maintaining healthy mushroom tissues by managing pests and diseases effectively. Regular monitoring for signs of infestation or infection is crucial, as early detection allows for timely intervention. Integrated pest management (IPM) strategies, such as introducing natural predators or using organic pesticides, can help control pests without harming the mushrooms. Similarly, disease management practices like proper sanitation, crop rotation, and the use of disease-resistant mushroom strains can minimize tissue damage. By addressing these underlying issues, growers can significantly reduce the risk of green mold taking hold.
Finally, strengthening the overall health of mushrooms through optimal growing conditions is essential in preventing green mold. Ensuring proper air circulation, maintaining appropriate temperature and humidity levels, and using high-quality substrate materials can bolster the mushrooms' natural defenses. Healthy mushrooms are better equipped to resist pests, diseases, and mold infections. Growers should also practice good hygiene, such as sterilizing equipment and avoiding contamination, to create an environment that discourages green mold growth. By focusing on tissue health and environmental management, the susceptibility of mushrooms to green mold can be effectively mitigated.
Mushrooms: Alkaline Superfood or Acidic Mystery?
You may want to see also
Frequently asked questions
Green mold on mushrooms is typically caused by Trichoderma, a common fungus that thrives in damp, humid environments. It can also result from contamination during cultivation or improper storage conditions.
Yes, green mold on mushrooms can be dangerous if consumed, as it may produce mycotoxins that are harmful to humans. It’s best to discard any mushrooms with green mold.
To prevent green mold, maintain proper humidity levels, ensure good air circulation, and store mushrooms in a cool, dry place. Avoid overcrowding and sanitize cultivation tools to minimize contamination.
Yes, green mold spores can easily spread to nearby mushrooms or plants, especially in humid environments. Isolate affected mushrooms immediately to prevent further contamination.
No, while Trichoderma is the most common cause of green mold on mushrooms, other fungi like Cladosporium or Penicillium can also appear green. Proper identification is key to addressing the issue effectively.











































